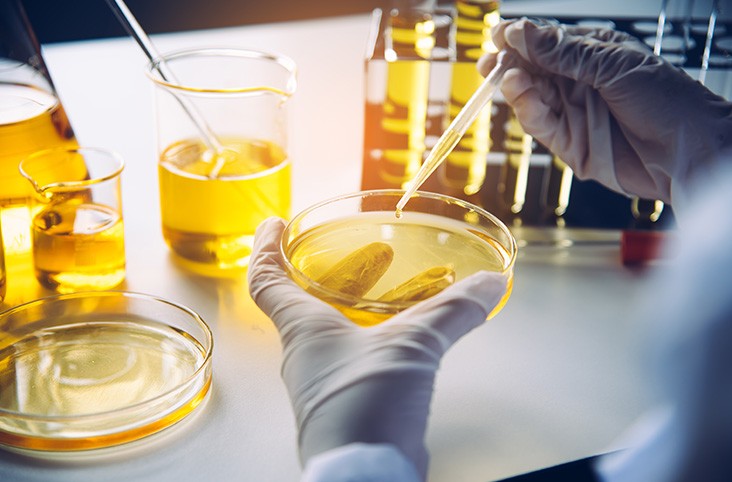
چکاپ فنی خودرو با آنالیز روغن 6 چکاپ روغن خودرو

آنالیز روغن خودرو
- HK-140406
چکاپ فنی خودرو با آنالیز روغن، بدون نیاز به باز کردن کارتر
<<< آنالیز سلامت موتور با ارائه برگه معتبر قانونی >>>
آنالیز روغن خودرو سنگین و لوکس | بررسی تخصصی سلامت موتور و گیربکس | تشخیص و پیشگیری زودهنگام خرابی موتور
شرکت حافظ خودرو
شماره ثبت ۶۰۵۹۱۸
همین حالا تماس بگیرید …
در بازار خرید و فروش خودروهای سنگین، دیزلی و سواریهای لوکس، دانستن وضعیت واقعی موتور بدون باز کردن قطعات، یک امتیاز مهم و نجاتبخش است. آنالیز روغن موتور، دقیقترین ابزار علمی برای ارزیابی سلامت موتور، گیربکس و اجزای حیاتی خودرو است؛ آن هم بدون نیاز به باز کردن کارتر یا ایجاد آسیب به ساختار فنی. این روش همانند یک آزمایشگاه تخصصی برای انسان عمل میکند؛ همانگونه که با یک آزمایش خون میتوان بیماریهای پنهان بدن را کشف کرد، با آنالیز روغن نیز میتوان مشکلات پنهان و آیندهدار خودرو را شناسایی و پیشگیری کرد.
شرکت حافظ خودرو دیزل با تکیه بر دانش فنی روز و تجهیزات تخصصی، این خدمات را بهصورت میدانی در محل خودرو یا دستگاه ارائه میدهد. نمونهگیری اصولی، ارسال به آزمایشگاه معتبر، و ارائه گزارش مستند به زبان فنی و قابل درک، بخشی از خدمات این مجموعه حرفهای است.
در واقع، آنالیز روغن پیش از خرید یا فروش، همان چکاپ فنی مطمئن است که میتواند جلوی خسارات میلیونی را بگیرد، تصمیم خریدار را بر پایه اطلاعات دقیق بنا کند، و معامله را بهسمت اطمینان و شفافیت پیش ببرد.
آنالیز روغن چیست و چرا برای خودروهای سنگین و لوکس اهمیت دارد؟
آنالیز روغن یا تحلیل تخصصی روغن مصرفشده موتور و گیربکس، روشی علمی و آزمایشگاهی برای بررسی سلامت فنی قطعات داخلی خودرو بدون نیاز به باز کردن آنهاست. در این فرآیند، نمونهای از روغن در حال کار خودرو برداشته و در آزمایشگاه از نظر فیزیکی، شیمیایی و فلزی مورد تجزیهوتحلیل دقیق قرار میگیرد.
در خودروهایی با قیمت بالا یا حساسیت مکانیکی، مانند کامیونهای دیزلی سنگین (ولوو، بنز، اسکانیا) و خودروهای سواری لوکس (بنز، بامو، لندکروزر، جنسیس)، دانستن وضعیت واقعی موتور و گیربکس بدون باز کردن قطعات داخلی، یک ضرورت اقتصادی و فنی بهشمار میرود. آنالیز روغن در این نوع وسایل نقلیه، همانند یک آزمایش خون برای انسان عمل میکند؛ با تشخیص زودهنگام علائم فرسایش، نشتی، خوردگی یا آلودگیهای غیرطبیعی، میتوان از خرابیهای بزرگ و پرهزینه پیشگیری کرد.
چرا این فرآیند حیاتی است؟
کاهش ریسک خرابیهای ناگهانی: سایش قطعات مانند یاتاقان، میللنگ یا سوپاپ پیش از بروز مشکل قابل شناسایی است.
پیشگیری از هزینههای سنگین تعمیرات: بهجای تعمیر بعد از خرابی، آنالیز روغن امکان پیشگیری بهموقع را فراهم میکند.
ارزیابی سلامت خودرو پیش از خرید: در معاملات خودروهای کارکرده یا وارداتی، این تحلیل نقش کلیدی در افزایش شفافیت دارد.
افزایش عمر مفید موتور و گیربکس: با اطلاع بهموقع از وضعیت روغن و آلودگیهای موجود، میتوان برنامه تعمیر و نگهداری را بهینه کرد.
آنچه در آنالیز روغن بررسی میشود
در فرآیند آنالیز روغن، نمونهای از روغن مصرفشده موتور، گیربکس یا سیستم هیدرولیک خودرو برداشته و در آزمایشگاه تخصصی تحت بررسی دقیق قرار میگیرد. این بررسی نهتنها خواص شیمیایی و فیزیکی روغن را مشخص میکند، بلکه از طریق آن میتوان فرسایش داخلی قطعات، آلودگیهای خارجی و کیفیت کلی روانکار مصرفشده را نیز ارزیابی کرد.
بررسی ترکیبات فلزی در روغن
حضور فلزات در روغن مصرفشده، نشانهای از سایش یا خوردگی قطعات داخلی موتور یا گیربکس است. آنالیز روغن بهصورت دقیق غلظت عناصر زیر را شناسایی میکند:
آهن (Fe): نشاندهنده سایش قطعات فولادی مانند میللنگ، سوپاپ، دندهها
مس (Cu): ناشی از خوردگی یاتاقانها یا بوشهای برنزی
آلومینیوم (Al): مرتبط با سایش پیستون، بلوک سیلندر یا قطعات آلومینیومی موتور
تحلیل خواص فیزیکی و شیمیایی روغن
ویژگیهای روانکاری روغن نیز در طول زمان دچار تغییر میشود. در آنالیز روغن، پارامترهای زیر بررسی میگردد:
گرانروی (Viscosity): بررسی مقاومت روغن در برابر جریان، که با افزایش دما و آلودگی کاهش یا افزایش مییابد
عدد قلیائیت کل (TBN): نشاندهنده قدرت روغن در خنثیسازی اسیدهای حاصل از احتراق؛ افت TBN نشانهی کهنگی یا آلودگی است
شاخص ویسکوزیته (VI): میزان پایداری ویسکوزیته در دماهای مختلف را نشان میدهد
شناسایی آلودگیهای خارجی
وجود مواد غیرطبیعی در روغن میتواند نشانهگر مشکلاتی مهم در سیستم باشد. ازجمله آلودگیهای قابل شناسایی:
آب (H₂O): نشانه ورود رطوبت یا نشتی در سیستم خنککننده
سوخت: نشاندهنده رقیقشدن روغن و احتمال احتراق ناقص یا نشتی انژکتور
ضدیخ: بیانگر نشتی در واشر سرسیلندر یا سیستم خنککاری
ذرات گرد و غبار: عامل سایش زودرس قطعات در صورت عملکرد ناقص فیلتر هوا یا ورود آلودگی از محیط
چه خودروهایی تحت پوشش این خدمات قرار میگیرند؟
آنالیز روغن بهعنوان یک روش تخصصی و بیطرفانه برای بررسی سلامت موتور، گیربکس و سیستمهای فنی، در انواع وسیلهنقلیههای سنگین، دیزلی و سواریهای لوکس قابل انجام است. این خدمت محدود به برند یا مدل خاصی نیست و کارشناسان شرکت حافظ خودرو دیزل با تجهیزات حرفهای، توانایی نمونهگیری و ارزیابی دقیق طیف گستردهای از خودروها و ماشینآلات را دارند.
خودروهای تحت پوشش آنالیز روغن شامل موارد زیر است:
🔸 کامیونهای سنگین بینالمللی و وارداتی:
ولوو FH، مرسدس بنز آکتروس، اسکانیا، دانگفنگ، مان، رنو، فاو
🔸 ماشینآلات راهسازی و معدنی:
لودر کوماتسو و چینی، بیل مکانیکی هیوندای و دوسان، بلدوزر کاترپیلار، گریدر، دامپتراک و اسکریپر
🔸 خودروهای لوکس خارجی و داخلی:
مرسدس بنز S-Class و E-Class، بامو X5 و سری ۷، تویوتا لندکروزر، هیوندای جنسیس، سانتافه، آزرا، کیا سورنتو، لکسوس RX و NX
🔸 خودروهای دیزلی ایرانی و مونتاژی:
بنز ۱۹۲۴، فوتون تونلند، آمیکو دیزلی، جک T8 دیزل، زامیاد دیزل، کاپرا ۲
اگر خودروی شما جزو موارد بالا نیست، نگران نباشید. کارشناسان فنی حافظ خودرو دیزل آمادهاند تا با بررسی اولیه، امکان آنالیز تخصصی روغن را برای هر نوع وسیله نقلیه بررسی و اجرا کنند.
📞 برای استعلام، مشاوره یا هماهنگی نمونهگیری با ما تماس بگیرید.
تجربهای دقیق، بیطرف و تخصصی در انتظار شماست.
مزایای آنالیز روغن برای خریداران خودرو
آنالیز روغن به خریداران خودرو، بهویژه خودروهای سنگین، دیزلی و لوکس، امکان میدهد پیش از انجام معامله، از وضعیت واقعی موتور و سیستمهای حیاتی خودرو آگاه شوند. این روش علمی و دقیق مزایای متعددی دارد که در ادامه به مهمترین آنها اشاره میکنیم:
شناسایی مشکلات پنهان پیش از خرید
بسیاری از خرابیها و فرسایشهای داخلی موتور یا گیربکس ممکن است ظاهراً نمایان نباشند. آنالیز روغن با بررسی ترکیبات فلزی و تغییرات شیمیایی، مشکلاتی مانند سایش یاتاقانها، خوردگی میللنگ، نشت ضدیخ یا آلودگیهای ناشی از سوخت را در مراحل اولیه کشف میکند.
جلوگیری از ضررهای ناشی از خرابی زودهنگام
تشخیص بهموقع عیوب و آلودگیهای روغن کمک میکند تا از خرابیهای ناگهانی و هزینهبر جلوگیری شود و عمر مفید موتور افزایش یابد.
افزایش شفافیت و اعتماد در معامله
با ارائه گزارش آنالیز روغن، خریدار و فروشنده هر دو از وضعیت فنی خودرو آگاه میشوند و معاملهای با اطمینان و بدون ریسک انجام میشود.
دریافت گزارش رسمی و مستند برای تصمیمگیری مطمئن
نتایج آنالیز روغن بهصورت گزارش تخصصی و قابل استناد ارائه میشود که میتواند بهعنوان مرجع فنی در فرآیند خرید، فروش یا تعمیرات مورد استفاده قرار گیرد.
خدمات تخصصی شرکت حافظ خودرو دیزل
شرکت حافظ خودرو دیزل با بهرهگیری از تیمی متخصص و تجهیزات پیشرفته، خدمات آنالیز روغن را به شکلی کامل و حرفهای ارائه میدهد تا خریداران و دارندگان خودروهای سنگین، دیزلی و لوکس بتوانند با اطمینان کامل از سلامت فنی خودروهای خود مطلع شوند.
خدمات کلیدی حافظ خودرو دیزل شامل موارد زیر است:
انجام نمونهگیری در محل:
کارشناسان ما با حضور در محل خودرو یا دستگاه، نمونهگیری اصولی و استاندارد روغن را به صورت دقیق انجام میدهند.ارسال نمونه به آزمایشگاه تخصصی:
نمونههای برداشت شده به آزمایشگاههای معتبر و مجهز ارسال شده و تحت بررسیهای تخصصی فیزیکی و شیمیایی قرار میگیرند.ارائه گزارش تحلیلی و قابلدرک:
نتایج آزمایش به شکل گزارش فنی، شفاف و قابل فهم برای خریداران تهیه میشود تا بهترین تصمیمگیری ممکن انجام شود.پشتیبانی فنی توسط کارشناسان مجرب:
پس از ارائه گزارش، تیم فنی حافظ خودرو دیزل پاسخگوی سوالات مشتریان بوده و راهنماییهای لازم برای نگهداری یا تعمیرات احتمالی ارائه میدهد.
چرا قبل از خرید خودرو سنگین یا لوکس، آنالیز روغن را جدی بگیرید؟
تجربههای واقعی مشتریان نشان میدهد که آنالیز روغن پیش از خرید خودرو، نه تنها از بسیاری از هزینههای تعمیرات سنگین جلوگیری میکند، بلکه باعث افزایش قابل توجه عمر مفید موتور و اجزای حیاتی خودرو میشود. این روش تخصصی، راهکاری علمی برای شناسایی مشکلات پنهان و نشانههای اولیه فرسایش است که به خریدار اجازه میدهد تصمیمی آگاهانه و کمریسک اتخاذ کند.
خرید خودرو بدون انجام تحلیل روغن، مانند پرواز بدون انجام چکاپ فنی پیش از پرواز است؛ خطرناک و پرریسک. با انجام آنالیز روغن، شما قادر خواهید بود به سلامت دقیق موتور و گیربکس اطمینان حاصل کرده و معاملهای مطمئن، بیخطر و هوشمندانه داشته باشید.
چرا باید آنالیز روغن را در حافظ خودرو دیزل انجام دهیم؟
شرکت حافظ خودرو دیزل به دلیل تخصص و تجربه بالا در زمینه آنالیز روغن، انتخابی مطمئن برای صاحبان خودروهای سنگین، دیزلی و لوکس به شمار میآید. این شرکت با بهرهگیری از کارشناسان حرفهای و تجهیزات پیشرفته، نمونهگیری روغن را بهصورت کاملاً اصولی و در محل خودرو انجام میدهد تا از صحت و کیفیت نمونه اطمینان حاصل شود. پس از برداشت نمونه، آن را به آزمایشگاههای تخصصی و مجهز ارسال میکند تا تحلیلهای دقیق و قابل اعتمادی صورت پذیرد. حافظ خودرو دیزل گزارشهای فنی را به شکلی شفاف و قابل فهم برای مشتریان تهیه میکند و علاوه بر ارائه گزارش، پشتیبانی فنی و مشاوره تخصصی را تا رفع کامل ابهامات و کمک به تصمیمگیریهای مهم ادامه میدهد. این رویکرد جامع و دقیق موجب صرفهجویی در هزینهها و کاهش زمان تعمیرات میشود و به خریداران و مالکان خودرو اطمینان میدهد که وضعیت فنی خودرو به درستی و با استانداردهای بالا بررسی شده است. به همین دلیل، انجام آنالیز روغن در حافظ خودرو دیزل تضمینی برای تصمیمگیری هوشمندانه و حفظ سرمایه شما محسوب میشود.
سوالات متداول آنالیز و چکاپ روغن
آنالیز روغن فرآیندی آزمایشگاهی است که نمونهای از روغن موتور یا گیربکس را بررسی میکند تا وضعیت سلامت قطعات داخلی، میزان آلودگیها، و تغییرات فیزیکی و شیمیایی روغن مشخص شود. این اطلاعات به شناسایی مشکلات پنهان، فرسایش و نیازهای نگهداری کمک میکند.
بله، آنالیز روغن برای انواع خودروهای سنگین، دیزلی، ماشینآلات راهسازی و خودروهای سواری لوکس قابل اجراست. کارشناسان ما با تجهیزات تخصصی، نمونهگیری و آزمایش دقیق را انجام میدهند.
انجام آنالیز روغن معمولاً در فواصل مشخص سرویسهای دورهای توصیه میشود، اما برای خودروهای دست دوم پیش از خرید و همچنین پس از مشاهده هر گونه علائم غیرعادی در عملکرد موتور یا گیربکس، تست ضروری است.
هزینه انجام آنالیز روغن بستگی به نوع خودرو، نوع روغن و شرایط نمونهگیری دارد و ممکن است متفاوت باشد. برای دریافت قیمت دقیق و مشاوره میتوانید با کارشناسان حافظ خودرو دیزل تماس بگیرید.
بله، گزارش آنالیز روغن شامل نتایج دقیق آزمایشها و تفسیرهای تخصصی است که به عنوان مدرک معتبر فنی میتواند در خرید، فروش یا برنامهریزی تعمیرات خودرو استفاده شود.